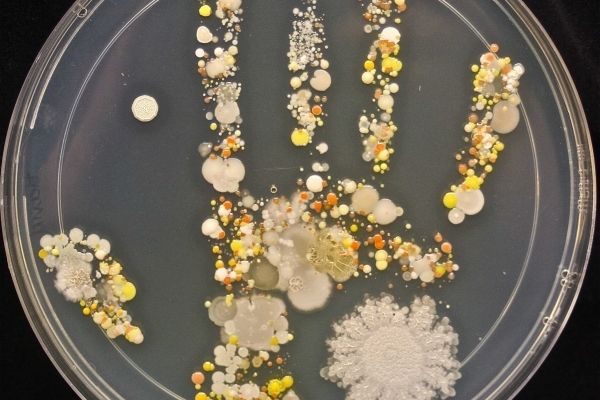

У Києві група розробників працює над пристроєм BIOsens, який має визначати кількість мікотоксинів у продуктах. Серед них і прикарпатець Андрій Карп’юк, пише – МІСТО.
Молодий науковець переїхав із Надвірної до Києва. Вчився в аграрному університеті, а потім об’єднав команду над однією ідеєю, а місяць тому про Андрія написав Financial Times – він потрапив у сотню інноваторів року, куди увійшло всього семеро людей з України.
Перегляньте також:
- На заході України діє шахрайська група,пов’язана з аферами з нерухомістю
- Село Лесівка Івано-Франківщини на столітніх фото австрійців
Днями винахідник повернувся з Мюнхена, від його ідеї в захваті новатори з усього світу, можливо тому, що в BIOsens є велика місія – врятувати людей від мікотоксинів, – йдеться у сюжеті ТСН.
Це шкідливі токсини, які можуть призвести до раку печінки та інших хвороб. Причиною утворення плісняви на продуктах є поліетиленові пакети, в яких зберігають харчі. Розробники працюють над тим, щоб тестер став доступним для кожного. Загалом на проект за приблизним розрахунками потрібно ще 200 тисяч доларів та трохи часу.